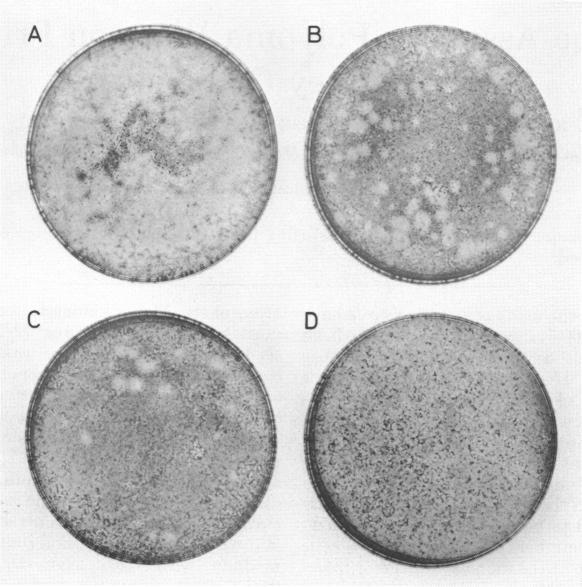

在原代小鼠肾细胞培养物上进行多瘤病毒的蚀斑测定。
Plaque assay for polyoma virus on primary mouse kidney cell cultures.
作者信息
Consigli R A, Zabielski J, Weil R
出版信息
Appl Microbiol. 1973 Oct;26(4):627-8. doi: 10.1128/am.26.4.627-628.1973.
Abstract
A plaque assay for polyoma virus using primary baby mouse kidney cells is reported.
摘要
报道了一种使用新生小鼠原代肾细胞进行多瘤病毒空斑试验的方法。